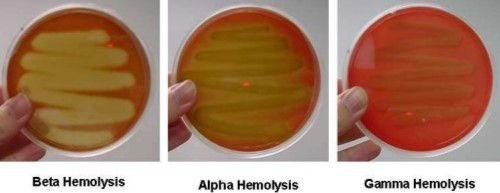

Estreptococcus crescem em ____- ou cadeias curtas, maioria tem respiração __________se cultiva preferivelmente em ágar ______, são catalase _____- e colonizam o ______ e pele
pares/ anaeróbia facultativa/sangue/ negativo/ trato respiratório
Estreptococcus são classificados segundo seu padrão hemolítico :
Beta hemolise: Pyogenes e Agalactiae. Dentro dos grupos de lancefild, Alfa hemólise: . Pneumoniae e viridans Gama hemolíticos: enterococcus
Classificação dos estreptococcus segundo grupos de lancefield:
A : -S. PYOGENES -S.ANGINOSUS B: -S.AGALACTIAE C: - S.DYSGALACTIAE F,G: - S.ANGINOSUS -S.DYSGALACTIAE Focar no A e B
Causa mais comum de faringite bacteriana (é um beta hemolítico)
S. pyogenes
Antígenos específicos dos S. pyogenes:
proteína M e Proteina F Cápsula de ácido hialurônico( forma de defesa contra hospedeiro)

Virulência dos S. pyogenes:
1) EVITA opsonização e fagocitose: -cápsula de ácido hialurônico -Proteína M bloqueia a ligação do sistema complemento 2) ADESÃO: -Proteína M -Proteína F -Ácido lipoteitóico (adesão inicial no epitélio) 3) TOXINAS:
Toxinas do S. pyogenes (6)
1-Toxinas ERITROGÊNICAS (aumenta secreção de citocinas pró-inflamatórias) 2-Estreptolisina S ( lisa eritrócitos e leucócitos - faz a beta hemólise no ágar) 3-Estreptolisina O (Lisa eritrócitos e plaquetas- Teste anti-aso) 4-Estreptoquinase A e B ( lisa coágulos sanguíneos) 5-Desoxirribonuclease (Degradam DNA) 6-Hialuronidase ( cliva ac. hialurônico)
Patologias supurativas relacionadas a S. pyogenes: (6)
1) Faringite 2) Escalartina (complicação da faringite- língua de morango) 3) Piodermia (impetigo- infecção de pele purulenta através de entrada em pele não íntegra) 4)Erisipela (infecção aguda da pele 5)Fascite necrozante (gangrena estreptocócica- subcutânea com destruição de músculo e tecido adiposo) 6) Síndrome do choque tóxico estreptocócico (inflamação de tecidos moles+bacteremia+fascite necrosante)

Patologias não supurativas relacionadas a S. pyogenes: (2)
1)Febre reumática: complicação da faringite 2) Glomerulonefrite: complicação da faringite e piodermia.
Diagnóstico laboratorial para S. pyogenes (3):
- Coloração de Gram 2. Testes imunológicos 3. Cultura: a) Swab da orofaringe - faringite b) Swab da base da lesão - impetigo c) Swab do tecido – fascite necrosante
Tratamento para S. pyogenes:
Sensíveis à penicilina via oral Amoxilina Resistencia: amoxilina + clavulanato Alergicos: cefalosporina oral Inicio da antibióticoterapia dentro dos 10 dias iniciais
Fatores de virulência dos S. agalactie (Grupo B : N-acetilglicosamina e galactose)
Polissacarídeo capsular
Colonização do S. agalactiae
Genital ( risco de infecção do bebê em parto prematuro )
Causa mais comum de sepse e meningite em recém nascido
S. agalactiae
A doença neonatal por Agalactiae pode ser dividida em :
1) início precoce (menor que 7 dias) -Sinais no útero ou primeira semana de vida -Bacteremina, pneumonia ou meningite 2) Início tardio (primeira semana a 3 semanas) - Exógeno - Associação de bacteremia à meningite
Tratamento para Agalactiae :
Tratamento: penicilina Arlergia: cefalosporina Rexistentes a macrolideos e tetraciclina Mulheres gravidas: penicilina G 4 horas antes do parto Mãe com risco de anafilaxia: vancomicina
Local de colonização dos S. viridans :
orofaringe, trato gastrointestinal e genitourinário
Virulência dp S. pneumoniae:
1)ácido teicoico 2)amidase 3)pneumolisina todos destroem tecidos 4) cápsula polissacaridica para classificação sorológica 5) Antígeno F

Colonização dos S. pneumoniae:
Pulmão (pneumonia), seios paranasais (sinusite) ou ouvido médio (otite)
Tipos de enterococcus de interesse clínico
E.feecalis E.faecium Causa mais frequente de infecções hospitalares PRINCIPALMENTE LIGADOS A SONDAS
Tratamento para S. Pneumoniae:
Vancomicina ceftriaxona vacina: -primeira dose com 2 meses -segunda dose com 4 meses -reforço aos 12 meses
Os estreptococcus são cocos gram positivos catalase negativos que tem crescimento inibido em meio com muita glicose. Vou F
V
O estreptococcus pyogenes é a causa mais comum de faringite bacteriana e é conhecido como bactéria carnívora. V ou F
V
O estreptococcus pyogenes é a causa mais comum de faringite bacteriana e é conhecido como bactéria carnívora. Vo u F
F ( proteína M)


